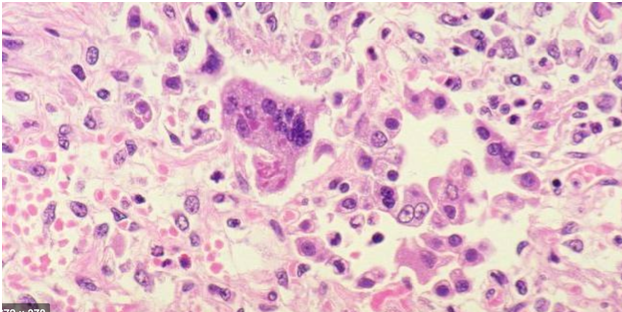
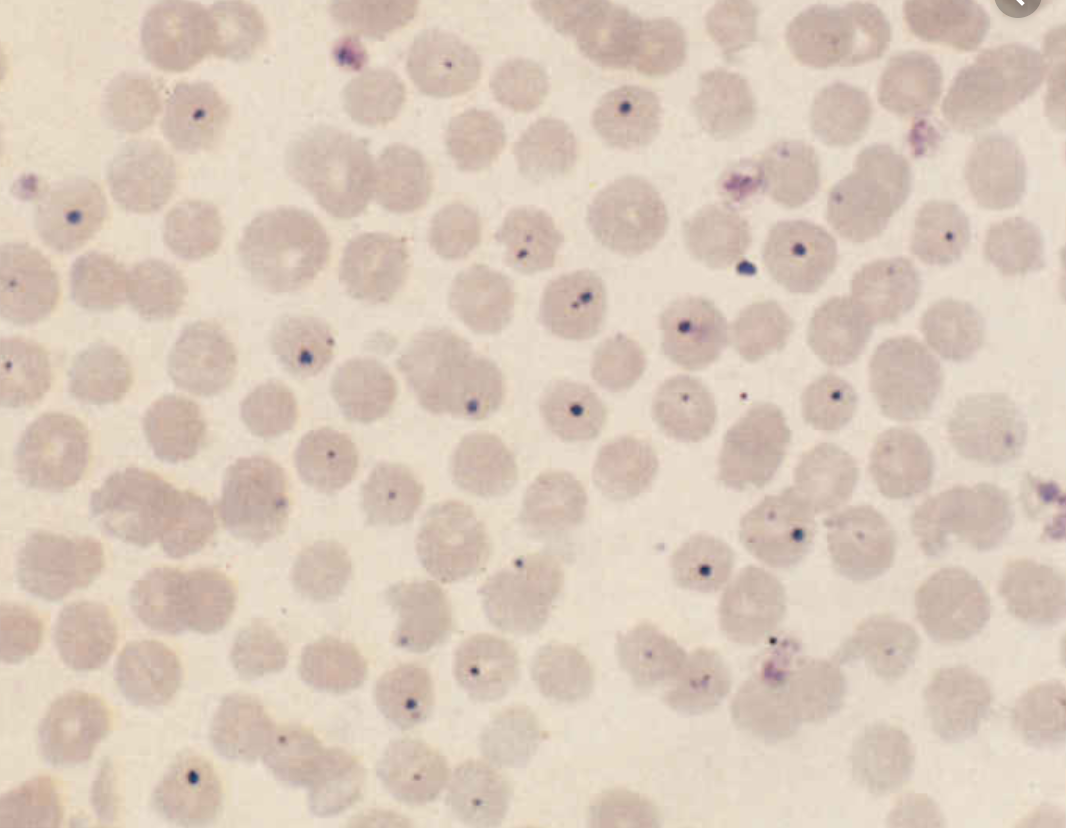
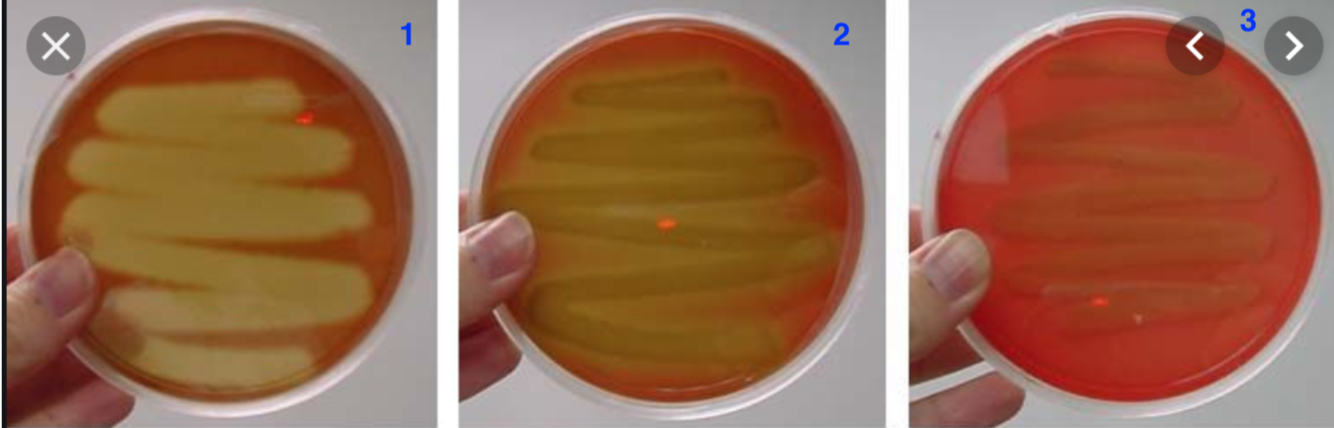
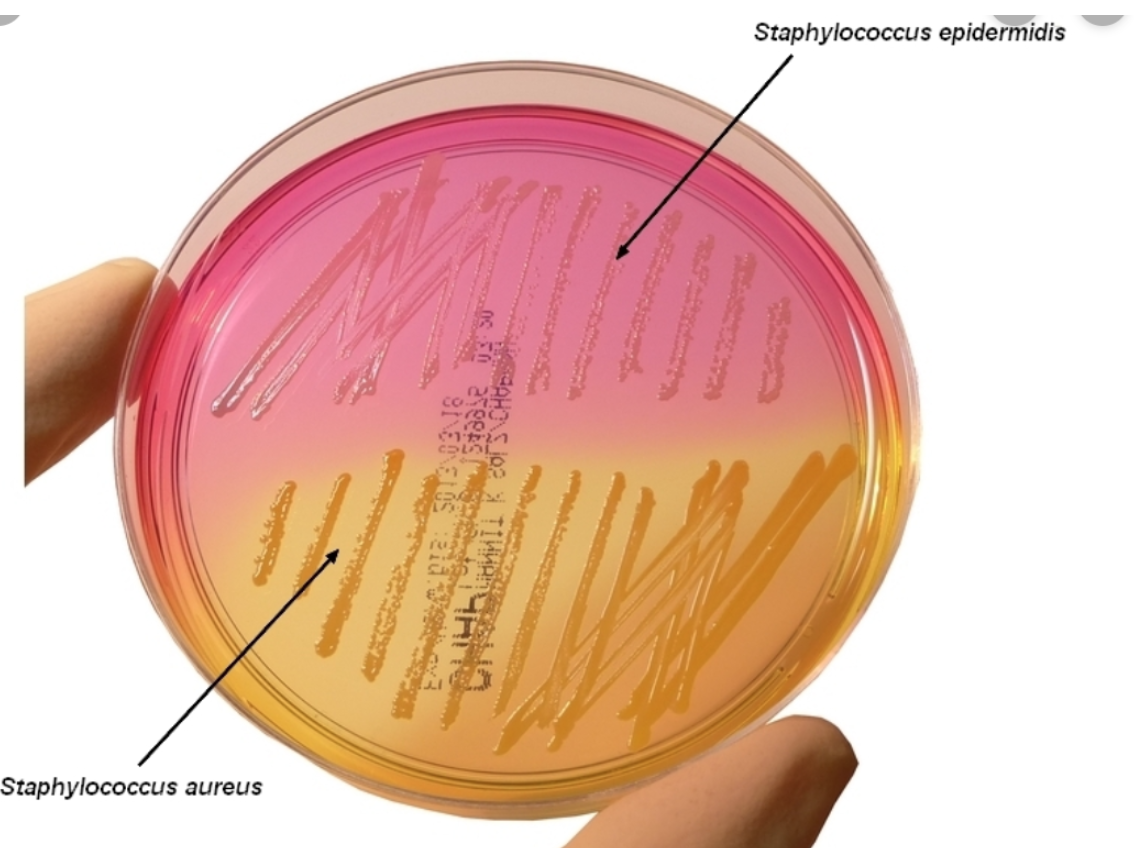

What are the basic steps that are involved in an ELISA test?
- Virus is on the surface 2. Enzyme with an antibody linked conjugate is added and then the sample is washed 3. Add a substrate and together these will create a colour change
What are the advantages of SNAP test technology over other systems?
speed, cost, accessibility
What are the disadvantages of SNAP test technology over other systems?
less accurate, not as precise
What are the different areas that you can inject into when inoculating eggs?
- Yolk sac 2. Allantois sac/cavity 3. Chorioallantoic membrane
Where is the endpoint in viral detection and quantification ?
the point at which partial or complete near agglutination occurs
What is the name of the virus below?
measles virus
Name the virus in the diagram below:
Anaplasma centrale and anaplamsa marginale
What is the name of the virus below?

Babesia
What is the process for carrying out a gram stain?
- Primary stain- crystal violet
- Mordant-iodine
- Decolouriser- acetone
- Counter strain- carbol fushin
Is pink gram negative or gram positive?
Pink is gram negative
Is purple bacteria gram positive or gram negative?
purple is gram positivie
Name the type of haemolysis present on the blood agar below:
- Beta hemolysis
- Alpha hameolysis
- Gamma haemeolysis
What is the use of mannitol salt agar?
S.aureus- turns yellow
S.epidermis- stays red
Normally the agar is pink/red
What species causes a psootive Dnase agar result with methyl green?
DNase hydrolysis - S.aureus
No DNAse hydrolysis= S.epidermis
What is a postive result for bile aesculin agar, what bacteria will give a positive result?
Enterococci and group D streptococci
What does MacConkey agar indicate, what is positive test result and what is a negative test result?
Lactose fermentors- have a pink-red colonies
Non-Lactose fermentors- these have as yellow like appearance/white
What is a postive result for a catalase test?
gass production
What is a positive result for a catalyse test?
coagulation of the the plasma
What is a positive result for the DNase activity test?
distinct clear zone around growth
What is a positive result for the indole test?
red colour in the re-agent layer
What is a negative result for the indole test?
Yellow colour in the re-agent layer
What is a positive result for the voges-proskaur effect?
a red colour
What is a postive result for the methyl red test?
a strong red colour
What is a positive result for citrate utilisation tests?
blue colour and visible growth


